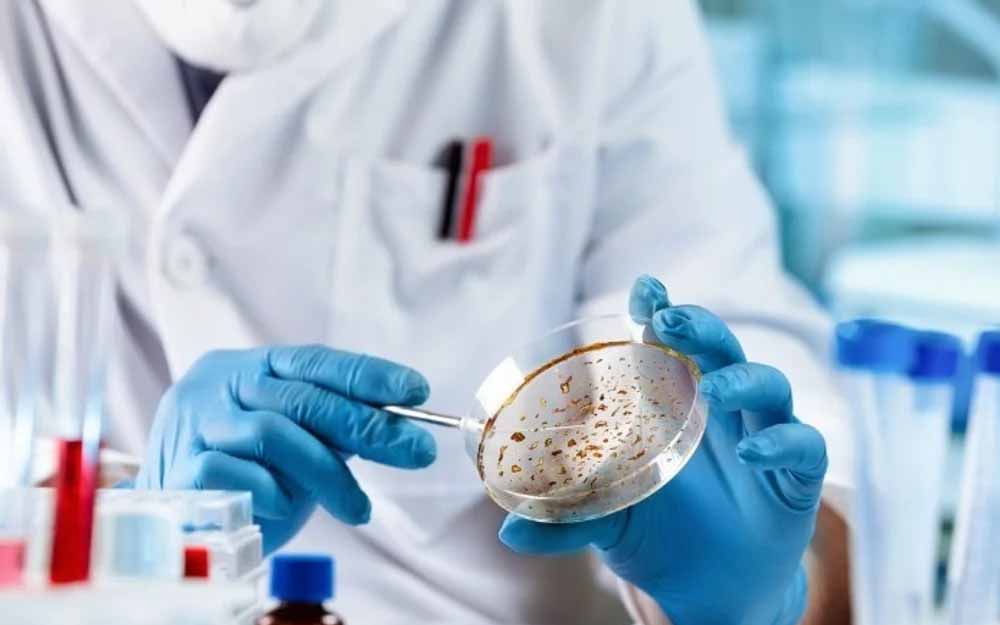

El objetivo es acelerar el descubrimiento de biomarcadores y nuevas terapias para cánceres infantiles.
Científicos australianos han desarrollado un catálogo pionero de cánceres pediátricos que ofrece nuevas y cruciales perspectivas para el avance de la inmunoterapia, específicamente diseñada para pacientes jóvenes.
El recurso, denominado Atlas del Modelo de Cáncer Infantil (CCMA) y con sede en el Instituto Hudson de Investigación Médica, alberga la colección más grande del mundo de más de 400 líneas celulares de cáncer pediátrico de alto riesgo.
Según el Instituto, esta base de datos está diseñada para pruebas y análisis de tratamientos impulsados por Inteligencia Artificial (IA).
La creación de este catálogo representa un esfuerzo por acelerar el descubrimiento de biomarcadores y nuevas terapias para cánceres infantiles.
Los cánceres pediátricos son una causa principal de muerte relacionada con enfermedades en niños y, a menudo, responden mal a las inmunoterapias diseñadas para adultos. Además, las terapias actuales pueden causar efectos secundarios duraderos en los cuerpos en crecimiento de los niños.
Los investigadores analizaron más de 200 líneas celulares de la colección del CCMA para identificar dos características cruciales para el sistema inmunológico:
El tipo de HLA (Antígenos Leucocitarios Humanos).
Los potenciales neoantígenos que cada línea celular presenta al sistema inmunitario.
La clave de los neoantígenos
Claire Xin Sun, autora principal del estudio del Instituto Hudson y la Universidad Monash, explicó la importancia de estos hallazgos:
"Los HLA son proteínas en la superficie de las células que el sistema inmunitario utiliza para distinguir entre lo 'propio' y lo 'ajeno'. Con esta información, predijimos qué neoantígenos podría producir y presentar cada modelo de cáncer".__IP__
Los neoantígenos son pequeñas piezas proteicas anormales que se forman cuando las células cancerosas mutan. Conocer el tipo de HLA es fundamental, ya que ayuda a determinar qué neoantígenos pueden ser reconocidos efectivamente por el sistema inmunitario.
El estudio, publicado en la revista iScience, ayudará a los investigadores a identificar cuáles tumores tienen antígenos procesables, convirtiéndolos en candidatos ideales para la inmunoterapia. El objetivo final es guiar el desarrollo de inmunoterapias más seguras y eficaces.
